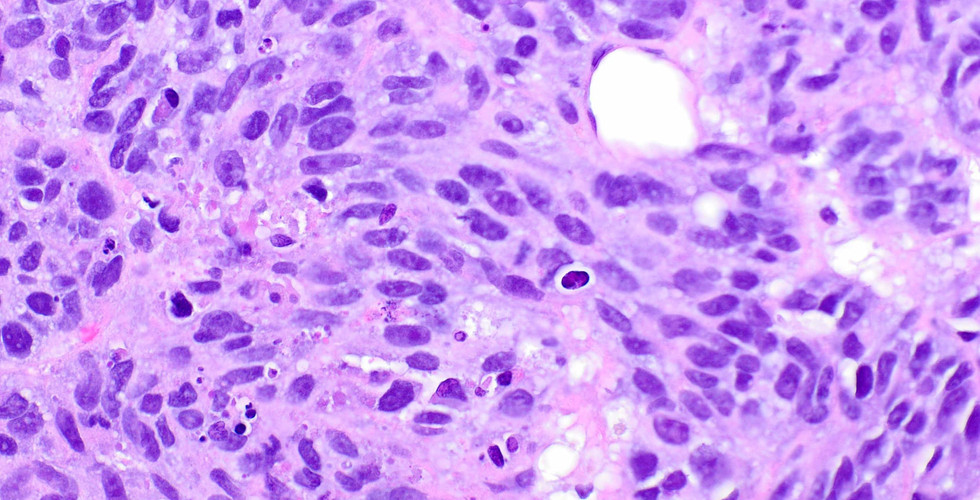

Sneaky Melanoma
- Elizabeth Montgomery, MD
- Dec 19, 2021
- 1 min read
This sneaky melanoma presented in a manner that resulted in a clinical diagnosis of breast carcinoma. Melanoma is so awful.
Case provided by Dr. Elizabeth Montgomery, Professor of Pathology and Vice Chair of Anatomic Pathology at the University of Miami, and Editor-In-Chief at Innovative Science Press. You can check out her Soft Tissue and GI Survival Guides as well as our new titles at:
info@innovativepathologypress.com
1-703-350-4308/703-340-3198
Fax: 1-855-661-7331